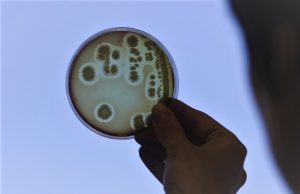

Etiket: enfeksiyon
COVİD-19’U EVDE GEÇİRİYORSANIZ BUNLARA DİKKAT!
Hastanelerde tedavi altında olan hastalar kadar, COVID-19’u hekim kontrolünde evde geçiren hastalar da oldukça yaygın. Peki bu hastalar evde nasıl davranmalı, diğer aile bireyleri...
SICAKLARDA GÖZLER DE RİSK ALTINDA
Yaz mevsiminde göz enfeksiyonları da önemli derecede artıyor. Yaz tatilinde havuz ve deniz kenarında serinlerken gözlerin de korunmasının enfeksiyonlardan korunmak için önemli olduğunu belirten...
SÜPER BAKTERİLERLE BÖYLE SAVAŞIN
Sağlık Bakanlığı’nın yaptığı tüm uyarı, aldığı tüm önlemlere rağmen kontrolsüz kullanımını azaltsa da önüne geçemediği antibiyotik tüketimi, antibiyotiğe dirençli bakterilerin gün geçtikçe artmasına neden...
PNÖMOKOK AŞISI HAYAT KURTARIYOR
Hem gelişmiş hem de gelişmekte olan ülkelerde görülme oranları giderek artan kalp yetersizliğinin önemli bir halk sağlığı problemi olması bakımından, bu konudaki toplumsal farkındalığın...